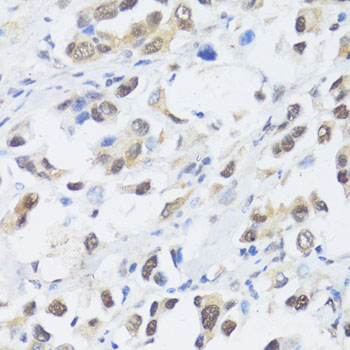

-
Product Name
EP300 Polyclonal Antibody
- Documents
-
Description
Polyclonal antibody to EP300
-
Tested applications
WB, IHC, IF
-
Species reactivity
Human, Mouse, Rat
-
Alternative names
EP300 antibody; KAT3B antibody; RSTS2 antibody; p300 antibody; E1A binding protein p300 antibody
-
Isotype
Rabbit IgG
-
Preparation
Antigen: Recombinant fusion protein containing a sequence corresponding to amino acids 1-270 of human EP300 (NP_001420.2).
-
Clonality
Polyclonal
-
Formulation
PBS with 0.02% sodium azide, 50% glycerol, pH7.3.
-
Storage instructions
Store at -20℃. Avoid freeze / thaw cycles.
-
Applications
WB 1:500 - 1:2000
IHC 1:50 - 1:200
IF 1:50 - 1:200 -
Validations

Western blot - EP300 Polyclonal Antibody
Western blot analysis of extracts of various cell lines, using EP300 antibody at 1:3000 dilution._Secondary antibody: HRP Goat Anti-Rabbit IgG (H+L) at 1:10000 dilution._Lysates/proteins: 25ug per lane._Blocking buffer: 3% nonfat dry milk in TBST._Detection: ECL Enhanced Kit ._Exposure time: 90s.

Immunohistochemistry - EP300 Polyclonal Antibody
Immunohistochemistry of paraffin-embedded rat ovary using EP300 antibody at dilution of 1:100 (40x lens).

Immunohistochemistry - EP300 Polyclonal Antibody
Immunohistochemistry of paraffin-embedded rat brain using EP300 antibody at dilution of 1:100 (40x lens).
Immunohistochemistry - EP300 Polyclonal Antibody
Immunohistochemistry of paraffin-embedded human lung cancer using EP300 antibody at dilution of 1:100 (40x lens).

Immunohistochemistry - EP300 Polyclonal Antibody
Immunohistochemistry of paraffin-embedded human breast using EP300 antibody at dilution of 1:100 (40x lens).

Immunohistochemistry - EP300 Polyclonal Antibody
Immunohistochemistry of paraffin-embedded mouse brain using EP300 antibody at dilution of 1:100 (40x lens).
-
Background
Functions as histone acetyltransferase and regulates transcription via chromatin remodeling. Acetylates all four core histones in nucleosomes. Histone acetylation gives an epigenetic tag for transcriptional activation. Mediates cAMP-gene regulation by binding specifically to phosphorylated CREB protein. Mediates acetylation of histone H3 at 'Lys-122' (H3K122ac), a modification that localizes at the surface of the histone octamer and stimulates transcription, possibly by promoting nucleosome instability. Mediates acetylation of histone H3 at 'Lys-27' (H3K27ac). Also functions as acetyltransferase for non-histone targets, such as ALX1, HDAC1, PRMT1 or SIRT2. Acetylates 'Lys-131' of ALX1 and acts as its coactivator. Acetylates SIRT2 and is proposed to indirectly increase the transcriptional activity of TP53 through acetylation and subsequent attenuation of SIRT2 deacetylase function. Acetylates HDAC1 leading to its inactivation and modulation of transcription. Acts as a TFAP2A-mediated transcriptional coactivator in presence of CITED2. Plays a role as a coactivator of NEUROD1-dependent transcription of the secretin and p21 genes and controls terminal differentiation of cells in the intestinal epithelium. Promotes cardiac myocyte enlargement. Can also mediate transcriptional repression. Acetylates FOXO1 and enhances its transcriptional activity. Acetylates BCL6 wich disrupts its ability to recruit histone deacetylases and hinders its transcriptional repressor activity. Participates in CLOCK or NPAS2-regulated rhythmic gene transcription; exhibits a circadian association with CLOCK or NPAS2, correlating with increase in PER1/2 mRNA and histone H3 acetylation on the PER1/2 promoter. Acetylates MTA1 at 'Lys-626' which is essential for its transcriptional coactivator activity. Acetylates XBP1 isoform 2; acetylation increases protein stability of XBP1 isoform 2 and enhances its transcriptional activity. Acetylates PCNA; acetylation promotes removal of chromatin-bound PCNA and its degradation during nucleotide excision repair (NER). Acetylates MEF2D. Acetylates and stabilizes ZBTB7B protein by antagonizing ubiquitin conjugation and degragation, this mechanism may be involved in CD4/CD8 lineage differentiation. In addition to protein acetyltransferase, can use different acyl-CoA substrates, such as (2E)-butenoyl-CoA (crotonyl-CoA), butanoyl-CoA (butyryl-CoA) or propanoyl-CoA (propionyl-CoA), and is able to mediate protein crotonylation, butyrylation or propionylation, respectively. Acts as a histone crotonyltransferase; crotonylation marks active promoters and enhancers and confers resistance to transcriptional repressors. Histone crotonyltransferase activity is dependent on the concentration of (2E)-butenoyl-CoA (crotonyl-CoA) substrate and such activity is weak when (E)-but-2-enoyl-CoA (crotonyl-CoA) concentration is low. Also acts as a histone butyryltransferase; butyrylation marks active promoters. Functions as a transcriptional coactivator for SMAD4 in the TGF-beta signaling pathway. Acetylates PCK1 and promotes PCK1 anaplerotic activity.; (Microbial infection) In case of HIV-1 infection, it is recruited by the viral protein Tat. Regulates Tat's transactivating activity and may help inducing chromatin remodeling of proviral genes. Binds to and may be involved in the transforming capacity of the adenovirus E1A protein.
Related Products / Services
Please note: All products are "FOR RESEARCH USE ONLY AND ARE NOT INTENDED FOR DIAGNOSTIC OR THERAPEUTIC USE"
